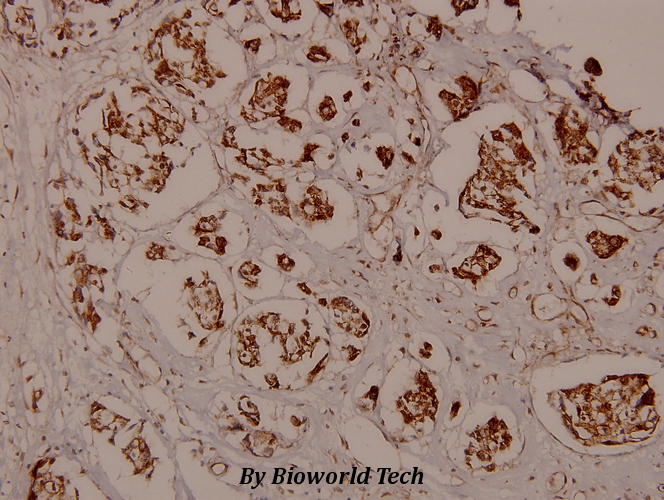

Product Name :
CaMKIIα (phospho-T286) polyclonal antibody Background :
The Ca2+/calmodulin-dependent protein kinases (CaM kinases) comprise a structurally related subfamily of serine/threonine kinases which include CaMKI, CaMKII and CaMKIV. CaMKII is an ubiquitously expressed serine/threonine protein kinase that is activated by Ca2+ and calmodulin (CaM) and has been implicated in regulation of the cell cycle and transcription. There are four CaMKII isozymes, designated α, β, γ and δ, which may or may not be co-expressed in the same tissue type. CaMKIIα is autophosphorylated on Thr 286 upon the binding of the Ca2+/CaM complex to the autoinhibitory domain of CaMKII. This process is called Ca2+/CaM trapping, which is thought to be involved in the synaptic encoding of information. Product :
Rabbit IgG, 1mg/ml in PBS with 0.02% sodium azide, 50% glycerol, pH7.2 Storage&Stability :
Store at 4°C short term. Aliquot and store at -20°C long term. Avoid freeze-thaw cycles. Specificity :
p-CaMK2-a (T286) polyclonal antibody detects endogenous levels of CaMK2-a protein only when phosphorylated at Thr286. Immunogen :
Synthetic phosphopeptide derived from human CaMKIIα around the phosphorylation site of Threonine 286. Conjugate :
Unconjugated Modification :
Phosphorylation
CaMKIIα (phospho-T286) polyclonal antibody Background :
The Ca2+/calmodulin-dependent protein kinases (CaM kinases) comprise a structurally related subfamily of serine/threonine kinases which include CaMKI, CaMKII and CaMKIV. CaMKII is an ubiquitously expressed serine/threonine protein kinase that is activated by Ca2+ and calmodulin (CaM) and has been implicated in regulation of the cell cycle and transcription. There are four CaMKII isozymes, designated α, β, γ and δ, which may or may not be co-expressed in the same tissue type. CaMKIIα is autophosphorylated on Thr 286 upon the binding of the Ca2+/CaM complex to the autoinhibitory domain of CaMKII. This process is called Ca2+/CaM trapping, which is thought to be involved in the synaptic encoding of information. Product :
Rabbit IgG, 1mg/ml in PBS with 0.02% sodium azide, 50% glycerol, pH7.2 Storage&Stability :
Store at 4°C short term. Aliquot and store at -20°C long term. Avoid freeze-thaw cycles. Specificity :
p-CaMK2-a (T286) polyclonal antibody detects endogenous levels of CaMK2-a protein only when phosphorylated at Thr286. Immunogen :
Synthetic phosphopeptide derived from human CaMKIIα around the phosphorylation site of Threonine 286. Conjugate :
Unconjugated Modification :
Phosphorylation
-

-
Immunohistochemistry (IHC) analyzes of p-CaMKIIα (T286) pAb in paraffin-embedded human breast carcinoma tissue at 1:100.
Immunohistochemistry (IHC) analyzes of p-CaMKIIα (T286) pAb in paraffin-embedded human breast carcinoma tissue at 1:100.
PKG II Inhibits EGF/EGFR-Induced Migration of Gastric Cancer Cells
PMCID: Pubmed No.:23613900
An integrated shotgun proteomics and bioinformatics approach for analysis of brain proteins from MCAO model using serial affinity chromatograph with four active ingredients from Shengmai preparations as ligands
PMCID: Pubmed No.:28049027
The effect of constitutive over-expression of insulin-like growth factor 1 on the cognitive function in aged mice
PMCID: Pubmed No.:26581336
ErbB1-dependent signalling and vesicular trafficking in primary afferent nociceptors associated with hypersensitivity in neuropathic pain
PMCID: Pubmed No.:32531343
Bioworld Biotech only provide peptides for our antibodies and do not provide additional peptide customization services.
Price/Size :
USD 368/1mg/vial
Tips:
For phospho antibody, we provide phospho peptide(0.5mg) and non-phospho peptide(0.5mg).Describe :
Blocking peptides are peptides that bind specifically to the target antibody and block antibody binding. These peptide usually contains the epitope recognized by the antibody. Antibodies bound to the blocking peptide no longer bind to the epitope on the target protein. This mechanism is useful when non-specific binding is an issue, for example, in Western blotting (WB) and Immunohistochemistry (IHC). By comparing the staining from the blocked antibody versus the antibody alone, one can see which staining is specific; Specific binding will be absent from the western blot or IHC performed with the neutralized antibody.Formula:
Synthetic peptide was lyophilized with 100% acetonitrile and is supplied as a powder. Reconstitute with 0.1 ml DI water for a final concentration of 10 mg/ml.The purity is >90%,tested by HPLC and MS.
Storage:
The freeze-dried powder is more stable. For short time at 2-8°C. For long term storage store at -20°C.
Note :
This product is for research use only (RUO only). Not for use in diagnostic or therapeutic procedures.
 CaMKIIα (phospho-T286) polyclonal antibody
CaMKIIα (phospho-T286) polyclonal antibody  Datasheet
Datasheet COA
COA MSDS
MSDS SHIP
SHIP